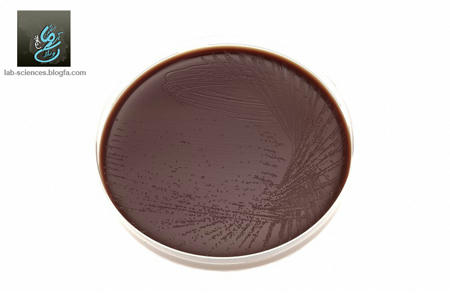
نایسریا گنوکوک

سلام ، فوت یکی از دوستان هم دانشکده ای عزیز را به خانواده داغ دارشان و همچنین دوستان هم دانشکده ای تبریزیم به ویژه دوستان رادیولوژی تسلیت عرض می گوئیم و امیدواریم که قرین رحمت باری تعالی باشند . به خاطر دیر آپ کردن وبلاگ عذر می خواهم انشا.... جبران می کنم . بعد مثل همیشه از لطف دوستان عزیز نسبت به وبلاگ نهایت تشکرو داریم . موفق باشین . راستی یادم رفت عید ولایتو بهتون تبریک می گوئیم . کلی حرف دارم ولی یادم میره !!! آهان! اگر هم کلاسی های من در یزد که ورودی ۸۹ بهمن هستن اومدن وبلاگ یه خبری به ما هم بدن مرسی! بعد اینکه لطفا نظر سیاسی و خارج از بحث نذارین تشکر(قابل توجه بعضی ها) !
در این پست هم طبق روال عادی وبلاگ چند لام مربوط به انگل شناسی را معرفی می کنیم . انتروبیوس ورمیکولاریس (اکسیور یا کرم سنجاقی) و کیست تک یاخته ژیاردیا لامهایی هستند که در زیر میتوایند آنها را مشاهده کنید . برای دیدن لام ها با کیفیت بالا بر روی آنها کلیک کنید .
مطالب مرتبط :
| اکسیور نر
با ادامه مطلب همراه ما باشید ....
ادامه مطلب